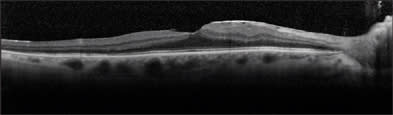
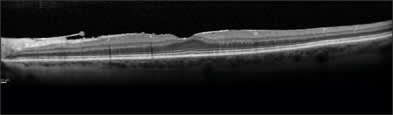

Diagnos-Tips
Some instruments can do more than you think they can.
BY JERRY HELZNER, SENIOR EDITOR
If you purchase a good electronic keyboard you can play it like a piano and be satisfied with that, or you can gradually explore all the other pleasing sounds you can get from the instrument — making the keyboard into an organ, perhaps even a harpsichord, and then adding various background rhythms.
Some diagnostic instruments are similar in that they have a primary use or uses for which they are well known, but they are versatile enough to also have additional productive uses that require a bit of creative thinking on the part of the ophthalmologist.
This article will explore some innovative ways that ophthalmologists have found to obtain additional value from their everyday diagnostic equipment. What is apparent from these anecdotal reports is that ophthalmic diagnostic technology has made stunning advances in recent years. It has even been reported that such precise information can now be gained from new technologies that small mammals that were routinely sacrificed in preclinical eyecare studies may in the future be spared because the necessary information can be obtained without killing the animal.
Macular Issues in Cataract Patients
Steven Safran, M.D., of Lawrenceville, N.J., originally purchased his Spectralis SD-OCT (Heidelberg Engineering) because he wanted to reduce his referrals to retina specialists.
"When I purchased the Spectralis, I thought it would be helpful to know what was going on with the macula in terms of cystoid macular edema and finding fluid in the retina associated with macular degeneration. I was tired of referring these patients out to the retina people every time I wasn't sure," he says. "After having it in my practice for a year, I've developed new applications for it as my understanding of the types of pathology that are really prevalent in the patient population has been refined. CME is not as common as lamellar holes — and the normal-looking macula nevus you may see can be associated with sub-retinal neovascularization and fluid. Epiretinal membranes (ERM) that look minimal can play a very significant role in macula distortion, whereas more serious-looking ERMs might not be causing a problem. The glaucoma analysis has been a tremendous asset as well, both for glaucoma and optic neuropathy."
Detecting these macular issues with the Spectralis has become key in Dr. Safran's evaluation of cataract patients for premium IOLs.
"I use the Spectralis to scan every premium lens patient prior to surgery and also for every cataract we do if the macula doesn't look perfect (and sometimes if it does but I'm just not sure)," says Dr. Safran. "We've picked up vitreomacular traction frequently, lamellar holes even more frequently, subretinal fluid, peripapillary disciform lesions with fluid leaking into the macula, subretinal nevi with subretinal neovascularization and fluid, and other issues prior to surgery that would have led to problems had we not known about it and gone ahead with the surgery. I do believe that the Spectralis allows me to ‘see’ the macula better than the best pair of eyes. I feel that examining the retina with a slit lamp and a lens is like having a satellite photograph, whereas the Spectralis images are like having a jeep on the ground."
Dr. Safran notes that cataract surgery patients have high expectations and premium IOL patients higher still.
"The problem you find before surgery is the patient's problem, but the problem you find after surgery becomes your problem, especially if that's the first time you become aware of it," he asserts. "Having a heads-up on these issues better allows us to choose the right surgical option, prepare the patient for realistic expectations and address retina and optic nerve issues before surgery rather than dealing with these issues for the first time after surgery."
Dr. Safran says that detecting macular issues in cataract surgery patients with the Spectralis has enabled him to implant the appropriate premium or monofocal IOL for these patients.
For example, Figure 1 is a 52-year old -4 myope who had a retinal detachment repair recently with buckle.

Figure 1. Despite a retinal detachment repair, this patient did well with a Crystalens IOL. Images courtesy of Steven Safran, M.D.
"The retinal detachment went right up to the edge of the macula and although the macula looks abnormal on exam, the Spectralis shows a rather normal macula architecture in this, his dominant right eye," says Dr. Safran. "This patient did extremely well with Crystalens in this eye, ending up 20/20 and J2 uncorrected.
"The next patient (Figure 2) also had Crystalens surgery in the dominant eye and did very well despite the presence of epiretinal membrane on exam. The OCT shows normal macula architecture, which indicates that, despite the ERM, the patient should do very well without problems."

Figure 2. Patient had an ERM, but SD-OCT showed normal macular architecture, which allowed a Crystalens implant.
(Though Dr. Safran uses the Spectralis, it should be noted that there are other advanced OCT instruments not specifically featured in this article that are also capable of providing helpful information to cataract surgeons.)
Evaluating Night Vision
"Most ophthalmologists relate wavefront aberrometry primarily to laser vision correction and pre- and postoperative refractive and cataract surgery issues," says Ernst Nicolitz, M.D., of Jacksonville, Fla., "but the 3-D Wave aberrometer by Marco Ophthalmic is demonstrating the increased diagnostic versatility of wavefront science in the area of routine refraction and the ever-common night vision problems that patients often report to us."
Dr. Nicolitz notes that the higher-order aberrations (HOAs), particularly 4th order spherical aberration in the Zernike polynomial of an eye, dramatically change as the pupil adjusts from smaller, photopic diameters to mesopic and scotopic larger, dilated pupils associated with night-vision conditions. He says that aberrometry measuring increased amounts (>0.4μ RMS) of HOAs, especially spherical aberrations in larger diameter pupils, suggests the potential etiology for night-vision problems.
Of even greater clinical significance in these increased amounts of HOAs is the varying degree of power changes they can produce in the lower-order aberrations (sphere/cylinder) as well.
"Our technicians and O.D.s find that these differences are commonly reflected between an autorefraction, usually at an instrument fixed, small-aperture size, (i.e., photopic pupil diameter) and a phoropter refraction, usually captured in a dimly lit exam room. Since the sphere and cylinder power in lower-order aberrations constitute the basis of current eyeglass, contact lens and even refractive surgery and IOL prescriptions, these lower-order differences may be noticeable to the patients in their day to night vision. Through a number of clinical trials at our practice, Nicolitz Eye Consultants, and undoubtedly among experienced eyecare practitioners, a sphere or cylinder differential of greater than 0.50 D and/or greater than a 5° to 10° axis shift in cylinder will be noticeable to most patients."
Thus, with an aberrometry measurement of increased HOAs (>0.4μ RMS) and a resultant, clinically significant differential (>0.50 D and/or 5° to 10° axis shift) in a lower-order prescription, along with a patient history of night-vision symptoms and complaints, Dr. Nicolitz asserts that a clinician can now demonstrate to patients the difference in their day and night vision.
"Based on the patient's visual needs (occupational, recreational, computer use), their final correction can be modified — or even a separate prescription can be provided — to address their night-vision issues," he concludes.
The Versatile Pentacam
While not highlighting one specific use for the Pentacam (Oculus), David R. Hardten, M.D., of Minneapolis, lauds the versatility of the instrument, which he calls the "best new diagnostic instrument."
Essentially, the Pentacam is a rotating Scheimpflug camera capable of measuring Scheimpflug images of the anterior eye segment. The Pentacam quickly calculates a three-dimensional mathematical model of the anterior segment to provide the following information: anterior and posterior corneal topography and elevation maps, corneal pachymetry from limbus to limbus, 3D-chamber analyzing, lens density, tomography and improved IOL calculation for post-LASIK, PRK and RK patients.
Dr. Hardten uses the Pentacam for a variety of diagnostic tests, including topography, photography and phakic IOL planning.
In phakic IOL planning, Dr. Hardten uses the High-Resolution (HR) model Pentacam to check before surgery to see if the phakic IOL will fit in the anterior chamber. The HR Pentacam software places a computer-generated phakic IOL in the anterior chamber and the doctor can see how it fits. After surgery, he can do an exam and see if the phakic IOL fits as well as the Pentacam predicted it would and be sure that it is not touching the endothelium. The software will also predict 5, 10 or 20 years out to show the doctor how the phakic IOL will fit then.
Michael W. Belin, M.D., of Albany, N.Y., and Renato Ambrósio Jr., M.D., Ph.D., of Brazil, have developed a software program for the Pentacam that enables clinicians to detect and quantify keratoconus and ectasia based on anterior topography and pachymetry data. The combined data can be shown in a single comprehensive display. This use of the Pentacam is particularly important for ophthalmologists performing preoperative tests on candidates for refractive surgery.
The ORA and Pneumatonometer
Two relatively inexpensive instruments from Reichert, Inc., have multiple uses that ophthalmologists will find to be of value. Both the Ocular Response Analyzer (ORA) and the pneumatonometer are both primarily used to measure IOP. However, they also have additional uses that may not be widely appreciated.
"The ORA measures the biomechanics of the cornea (corneal hysteresis) allowing us insight into a potential new metric for evaluating glaucoma," says Malik Kahook, M.D., of Denver. "We know that corneal thickness is not a direct correlate for how the cornea reacts to mechanical forces such as indentation by Goldmann tonometry as well as deformations that might occur with high IOP. While still requiring many more studies for understanding and validating data obtained from ORA, I do believe the device has potential to yield data helpful in diagnosing and following glaucoma patients. It has been particularly helpful in patients whose corneal compensated pressures were measured as significantly higher than the Goldmann applanation pressure, thus providing insight into why some patients might progress despite what appears to be lower IOP. Future studies should help define how to use this information in daily practice."
Currently, there is a Category III code for corneal hysteresis testing, 0181T, with reimbursement determined by the local carrier. In order for a CAT III code to become CAT I, where reimbursement is easier, significant evidence of reimbursement activity and a body of scientific evidence to support the new device is needed.
Dr. Kahook also notes that while it is well known that glaucoma is a disease of aqueous outflow (rather than increased production of aqueous), there is still no consistent way to measure outflow facility in the clinical setting.
"Tonography using Schiotz tonometry had been used in the past but fell into disfavor for various reasons, including difficulty in obtaining reproducible data as well as the cumbersome nature of the device hardware," notes Dr. Kahook. "Pneumatonometry offers an alternative way for performing tonography and can be a valuable research tool when performed by those with proper training. I mainly use pneumatonography for clinical research studies and have found it to be of particular help when defining the mechanism of new anti-glaucoma medications."
Insights from Specular Microscopy
The CellChek XL specular microscope (Konan) offers several innovative uses, primarily related to obtaining accurate endothelial cell counts.
Todd Fladen, M.D., of Canton, OH, uses the CellChek preoperatively for all cataract surgery patients.
"There is a significant cost differential between generic BSS and BSS Plus, so it is important that we use each appropriately," he notes. "Patients with low endothelial counts and guttata get BSS Plus and those with normal cell counts receive BSS. Using the microscope ensures an accurate count and allows me to provide the best care in a cost-effective manner. Also, by using the microscope I can easily document which patients need BSS Plus and which can receive BSS."
George Rosenwasser, M.D., of Hershey, Pa., finds numerous innovative uses for the CellChek XL.
"There are many uses for specular microscopy. The common ones would be ruling in or out Fuchs' corneal dystrophy and checking the condition of a cornea before surgery if it has had multiple previous anterior segment procedure," he notes. "There are, however, some unique ways to use this method of testing. Several involve high indexes of suspicion of other things going on, sometimes they involve events leading up to a necessary investigation of the cornea."
Dr. Rosenwasser says genetics also make up a large part of indications for specular microscopy, as do surgical misadventures.
"One of the interesting silent causes of corneal edema is nonguttatae endothelial dystrophy. The cornea looks extensively normal unless one can actually count the cells through specular reflection and after routine anterior segment surgery, the eye develops irreversible corneal edema. Examination of the fellow eye frequently shows what was not expected, a very low cell count, in an otherwise normal-appearing cornea. Any significant compromise then can cause decompensation."
Dr. Rosenwasser mentions other disease processes that are also fairly silent and do not show signs of routine guttatae, like Fuchs' dystrophy, include posterior polymorphic dystrophy, a disease where epithelialization of the endothelium occurs.
"Occasionally, some light lines or cyst-like changes are seen on the cornea, perhaps in an isolated area," he says. "This can be further evaluated with specular microscopy to show the full extent of cell changes. Bizarre cells, which appear dark with light borders as opposed to light with dark borders, indicate an abnormality of the cells. Posterior polymorphic dystrophy typically is an autosomal dominant corneal dystrophy and can be seen in family members such as the parents or children of the individual examined."
Regarding trauma, whether it is physical trauma during a motor vehicle accident or iatrogenic trauma, Dr. Rosenwasser advocates evaluating the cornea with a specular microscope. Airbags and blunt force trauma can cause detachment of endothelial cells, damaging them and causing death of those cells. Corneal edema can be immediate and the remaining cell populations can be assessed when the cornea is cleared. Iatrogenic forms of physical damage include toxic anterior segment syndrome (TASS). Even if TASS clears, the introduction of an abnormal fluid into the anterior segment, an unusual ionic compound or other material, such as detergent, can cause substantial inflammatory changes and these changes can cause endothelial cell loss. Dr. Rosenwasser says specular microscopy is an excellent way to evaluate the extent of this and the likelihood of long-term corneal survival.
"I like to use specular microscopy as a preoperative evaluative tool in some other more commonly seen situations such as pre-LASIK and keratoconus patients prior to DALK. Both of these procedures can have some affect on the corneal endothelium. The use of a microkeratome can cause flexing of the endothelial layer and potentially cause some damage," he asserts. "In cases of Fuchs' dystrophy, it has previously been seen that the actual act of using the microkeratome and then performing LASIK has caused decompensation of the Fuchs' dystrophy when it, otherwise, might have remained dormant for years. Unfortunately, this has been detected postoperatively. Knowing that there is an adequate cell population prior to going to the trouble of doing a DALK procedure can save the surgeon and patient several hours of operating time. If there is not a good cell population, it certainly is not worth using the DALK technique, but a full-thickness PKP might be indicated."
There are some ophthalmic conditions that may have a long-term effect on endothelial cell counts such as advanced glaucoma with poorly controlled IOP or contact lens over wear intolerance. Dr. Rosenwasser says these can similarly be monitored by specular microscopy.
"I also follow my transplants using specular microscopy to tell whether a particular technique, type of donor tissue or preservation-cycle length of time has a significant effect on the donor cornea. The only way to detect this is to follow the patient at various time gates after the surgery to see how the tissue is doing compared to other types of procedures."
Finally, Dr. Rosenwasser appreciates the educational aspects of specular microscopy, which adds clarity in terms of demonstrating to the patients what is really going on at a microscopic level in their eye.
"For examination of the cornea, the holy grail of our subspecialty is really the corneal endothelium. Knowing the condition of this membrane is as important as being able to do a cardiogram or seeing the coronary arteries for a cardiologist dealing with a heart patient," concludes Dr. Rosenwasser.
Atlas 9000 Corneal Topographer
Kevin Waltz, M.D., of Indianapolis, uses the Atlas 9000 from Carl Zeiss Meditec for a range of preop analysis tests, including measuring for astigmatism, identifying keratoconus and diagnosing corneal disease.
However, he also uses the Atlas preoperatively to identify corneal irregularities that indicate dry eye disease.
"Certain surface irregularities enable me to diagnose dry eye prior to cataract surgery," he says. "I then postpone the surgery for about a month and treat for dry eye. By treating for dry eye first, I avoid significant postop issues that would have otherwise occurred in these patients."
Technology + Creativity = Innovation
What the foregoing examples demonstrate is that the combination of superior technology and physician creativity can be a potent one, with benefits accruing to patients, physicians and the companies that bring these instruments to the marketplace. OM








